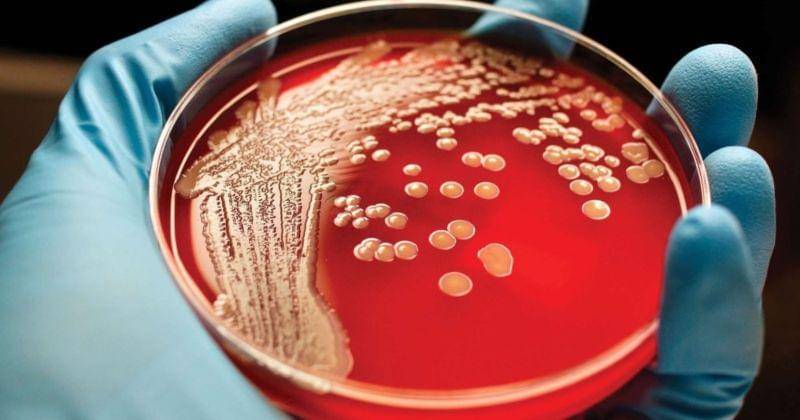
meconferences.com

- Ada riwayat penyakit turunan yang mengganggu imun tubuh
- Memiliki saudara kandung yang menderita sakit leukimia
- Riwayat pada sistem imun seperti transplantasi organ
- Karena ada riwayat paparan kemoterapi, radiasi, benzena dengan ukuran yang tinggi
Kenali Jenis Kanker Darah yang Sering Menyerang Usia Lanjut

Darah terdiri dari berbagai jenis sel termasuk sel darah merah untuk membawa oksigen, trombosit untuk membantu pembekuan darah dan sel darah putih yang melawan infeksi. Mereka semua awalnya berasal dari sel batang, yang memiliki potensi untuk berkembang menjadi semua jenis sel darah saat mereka membelah.
Masalah dalam proses ini, yang dikenal sebagai 'diferensiasi', adalah akar dari semua kanker darah. Berbagai jenis kanker darah tergantung pada kapan dan bagaimana masalah ini terjadi.
Masalah-masalah ini sering menyebabkan tubuh memproduksi sejumlah besar sel darah imatur yang tidak dapat melakukan tugasnya dengan baik. Mereka juga dapat 'menyumbat' sumsum tulang, yang mencegah pekerjaan sel darah lain.
Kanker darah atau juga bisa disebut kanker hematologi merupakan penyakit kanker yang memengaruhi produksi dan fungsi sel darah.
Berikut uraian yang diberikan Popmama.com tentang jenis, pencegahan, penyebab, dan pengobatan pada penderita kanker usia lanjut.
1. Jenis kanker darah yang sering menyerang usia lanjut
Secara umum kanker darah dibagi ke dalam 3 jenis yaitu leukimia, myeloma, dan limfoma. Kanker darah yang banyak menyerang usia lanjut yakni myloma dan limfoma. Namun, tidak menutup kemungkinan usia lanjut juga mengalami leukimia (kanker sel darah putih).
Leukimia adalah kanker yang ditemukan dalam darah dan sumsum tulang, disebabkan oleh produksi sel darah putih abnormal yang cepat. Tingginya jumlah sel darah putih abnormal tidak mampu melawan infeksi, dan dapat merusak kemampuan sumsum tulang untuk menghasilkan sel darah merah dan trombosit.
Kanker darah limfoma adalah jenis kanker darah yang memengaruhi limfosit. Limfosit merupakan sel darah putih yang membentuk bagian sistem kekebalan dan membantu melawan infeksi. Tubuh akan memiliki 2 jenis utama limfosit, yaitu sel B dan sel T.
Pada limfoma, baik limfosit B atau T menjalani perubahan yang jinak, dan karena itu dapat membelah dan berkembangbiak tanpa terkendali. Limfosit yang dikatakan abnormal ini tidak berfungsi sebagaimana harusnya dan mengerubungi sel yang sehat.
Limfoma memengaruhi fungsi normal sistem kekebalan dan akan mengurangi daya tahan tubuh penderitnya terhadap faktor berbahaya dari luar. Kanker jenis ini juga memengaruhi kelenjar getah bening, limpa, timus, sumsum tulang, dan bagian lain dari tubuh.
Terdapat 2 jenis utama kanker limfoma yakni Hodgkin Lymphoma (HL), umumnya terjadi pada orang dewasa usia muda antara 15 dan 30 tahun, dan dewasa berusia di atas 50 tahun. Lalu, Non-Hodgkin Lymphoma (NHL) yang umum pada orang lanjut usia.
Selain itu ada myeloma, jenis kanker yang terbentuk oleh sel plasma ganas. Sel plasma diketahui menghasilkan antibodi atau immunoglobulin yang membantu tubuh menyerang dan membunuh kuman. Sel plasma normal ditemukan di dalam sumsum tulang dan merupakan bagian sistem imun yang penting.
Kanker darah jenis ini mencegah produksi antibodi normal yang bisa mengakibatkan sistem kekebalan tubuh menjadi lemah dan rentan terhadap infeksi. Umumnya risiko terkena kanker jenis ini meningkat seiring bertambahnya usia, kebanyakan penderita kanker ini berusia setidaknya 65 tahun.
2. Penyebab terjadinya kanker darah

Secara umum para ahli masih belum mengetahui dengan pasti penyebab kanker darah. Tetapi, perubahan dalam DNA bisa membuat sel-sel darah yang sehat menjadi kanker, itu dugaan dari para ahli.
Kanker darah juga memiliki kecenderungan genetik. Jika keluarga terdekat seperti orangtua, saudara kandung, nenek atau kakek memiliki riwayat penyakit ini, bisa jadi kamu berisiko untuk menderita penyakit ini.
Faktor-faktor lain yang juga bisa menyebabkan kanker darah yakni paparan bahan kimia berbahaya, paparan radiasi, serta infeksi virus tertentu.
Ada beberapa orang yang berisiko terkenan kanker darah dan dari setiap jenis kanker darah itu memiliki risiko yang berbeda:
Leukimia
Limfoma
- Berusia sekitar atau lebih dari 60 tahun
- Memiliki penyakit rheumatoid arthritis (rematik), sindrom Sjogren, lupus, atau penyakit Celiac
- Memiliki riwayat penyakit limfoma Hodgkin atau limfoma non-Hodgkin saat dulu
- Sedang menjalani pengobatan kemoterapi karena kanker lainnya
Myeloma
- Memiliki riwayat penyakit autoimun, seperti diabetes, lupus, rheumatik arthritis, psoriasis, dan lain sebagainya
- Memiliki berat badan atau obesitas yang bisa meningkatkan risiko berkembangnya myeloma
- Kanker jenis ini meningkat seiring bertambahnya usia dan kebanyakan penderita kanker ini berusia setidaknya 65 tahun
- Memiliki riwayat keluarga dengan penyakit ini
- Terpapar radiasi tingkat tinggi (bom atom) atau tingkat rendah dalam waktu lama (karena pekerjaan khusus)
3. Gejala jika terkena penyakit kanker darah

Gejala kanker darah berbeda-beda tergantung jenisnya, berikut gejala yang terjadi pada ketiga tipe kanker darah.
Leukimia
- Anemia
- Darah sukar membeku
- Sering mengalami perdarahan seperti mimisan, gusi berdarah, atau memar
- Rentan terkena infeksi
- Nyeri pada persendiannya atau di bagian tulang belakang
- Sakit kepala yang intens
Limfoma
- Adanya tonjolan di bawah kulit, biasanya di selangkangan, leher, atau ketiak
- Selalu merasa lemah, lesu, dan tidak bersemangat
- Keringat berlebih di malam hari
- Muncul darah dalam tinja atau muntah
- Haid dengan volume darah yang berlebihan
Myeloma
- Anemia
- Sering mengalami perdarahan dan memar
- Gangguan tulang dan kalsium sehingga menyebabkan tulang mudah patah
- Rentan mengalami infeksi
- Gangguan atau kerusakan ginjal
- Kaki yang bengkak
4. Pengobatan

Pengobatan kanker darah tergantung pada berbagai faktor seperti jenis kanker, penyebaran kanker, usia pasien dan lainnya. Pengobatan kanker termasuk di dalamnya.
- Terapi radiasi: Prosedur ini dapat digunakan untuk menghancurkan sel-sel kanker atau mengurangi rasa nyeri dan tidak nyaman saat gejala kanker darah muncul.
- Kemoterapi: Kemoterapi adalah penggunaan obat antikanker yang dirancang untuk mengganggu dan menghentikan pertumbuhan sel-sel kanker dalam tubuh.
- Terapi target: Terapi target adalah terapi yang menggunakan obat-obatan atau bahan kimia lain untuk mengidentifikasi dan menyerang sel kanker secara spesifik tanpa membunuh sel-sel normal.
- Transplantasi stem cell: Transplantasi stem cell akan menanamkan stem cell pembentuk darah yang sehat ke dalam tubuh.
Kamu harus konsultasikan dengan dokter untuk pilihan terapi dan obat kanker yang tepat. Setiap pengobatan penyakit ini memiliki efek samping yang berbeda-beda. Pertimbangkan juga risiko pengonsumsian obat kanker dengan kondisi tubuhmu.
5. Cara pencegahan

Sedia payung sebelum hujan, untuk mencegah agar tidak terkena kanker darah ternyata dapat dilakukan dengan cara yang sederhana lho, seperti:
- Berolahraga secara teratur untuk menjaga tubuh tetap kuat
- Disiplin dalam menerapkan gaya hidup sehat
- Hindari bahan makanan yang memakai herbisida, pestisida, dan insektisida
- Hindari paparan radiasi
- Makan makanan sehat dan mengurangi makanan seperti olahan daging mentah, makanan instan, junkfood, makanan kaleng, dan makanan atau minuman yang mengandung pemanis buatan.
- Sering minum banyak air putih minimal 1,5 liter atau 8 gelas perhari
- Minum obat secara teratur sesuai dengan yang diresepkan dokter
Bila kamu mengalami tanda-tanda dan gejala kanker darah yang sudah disebutkan di atas dan khawatir akan gejala itu. Tak perlu ragu untuk memeriksakannya ke dokter.
Mencegah lebih baik daripada mengobati, untuk itu mulai sekarang terapkan hidup sehat agar mencegah terjadinya penyakit tersebut.
Baca juga:



















